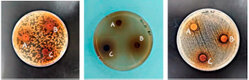

Language
Indexing
Indexing & Discovery
OpenAlex
Google Scholar
Crossref DOI
Dimensions
ProQuest
Scilit
Semantic Scholar
Latindex Catálogo 2.0
MIAR
Index Copernicus
Preservation
LOCKSS
CLOCKSS
Official OJS Repository
Journal Information
ISSN: 3020-7886
DOI Prefix: 10.70099
Diamond Open Access
CC BY 4.0
Citation Highlights
Selected from current citation data indexed in Scopus and Google Scholar.
Scopus
- Bioactive components of sambo seeds, almonds and honey and their relationship with prostate cancer Vol. 2 (2025)
- Physicochemical composition and amino acid profile of the beverage of Ungurahua (Oenocarpus bataua) from the Amazonian Region of Ecuador Vol. 1, No. 3 (2024)
- Morphogenetic identification of new endophytic fungal species related to the family of Plectosphaerellaceae in Iraq Vol. 1 (2024)
- Effect of different phytohormones on in vitro multiplication of Solanum tuberosum L. var. Cecilia Vol. 1 (2024)
- Edible mushroom production in Ecuador: opportunities for biotechnological use of agricultural by-products Vol. 1 (2024)
Google Scholar
- Antioxidant and anti-diabetic effects in vitro of extract from the above-ground parts of Acanthus ilicifolius Vol. 1, No. 3 (2024)
- Assessment of the biological activities of Azolla pinnata growing in the North-West of Algeria Vol. 1, No. 3 (2024)
- Pioneering the Future of Organ Transplantation: Lessons from the Spanish Model Vol. 2, No. 1 (2025)
- Liquid Biofuel Production in Eastern Africa: The Sustainability Challenge of Land and Feedstock Availability Vol. 1, No. 4 (2024)
- Biological nematicides as an alternative for control of Meloidogyne incognita populations in yellow pitahaya (Sselenicereus megalanthus) Vol. 1, No. 1 (2024)